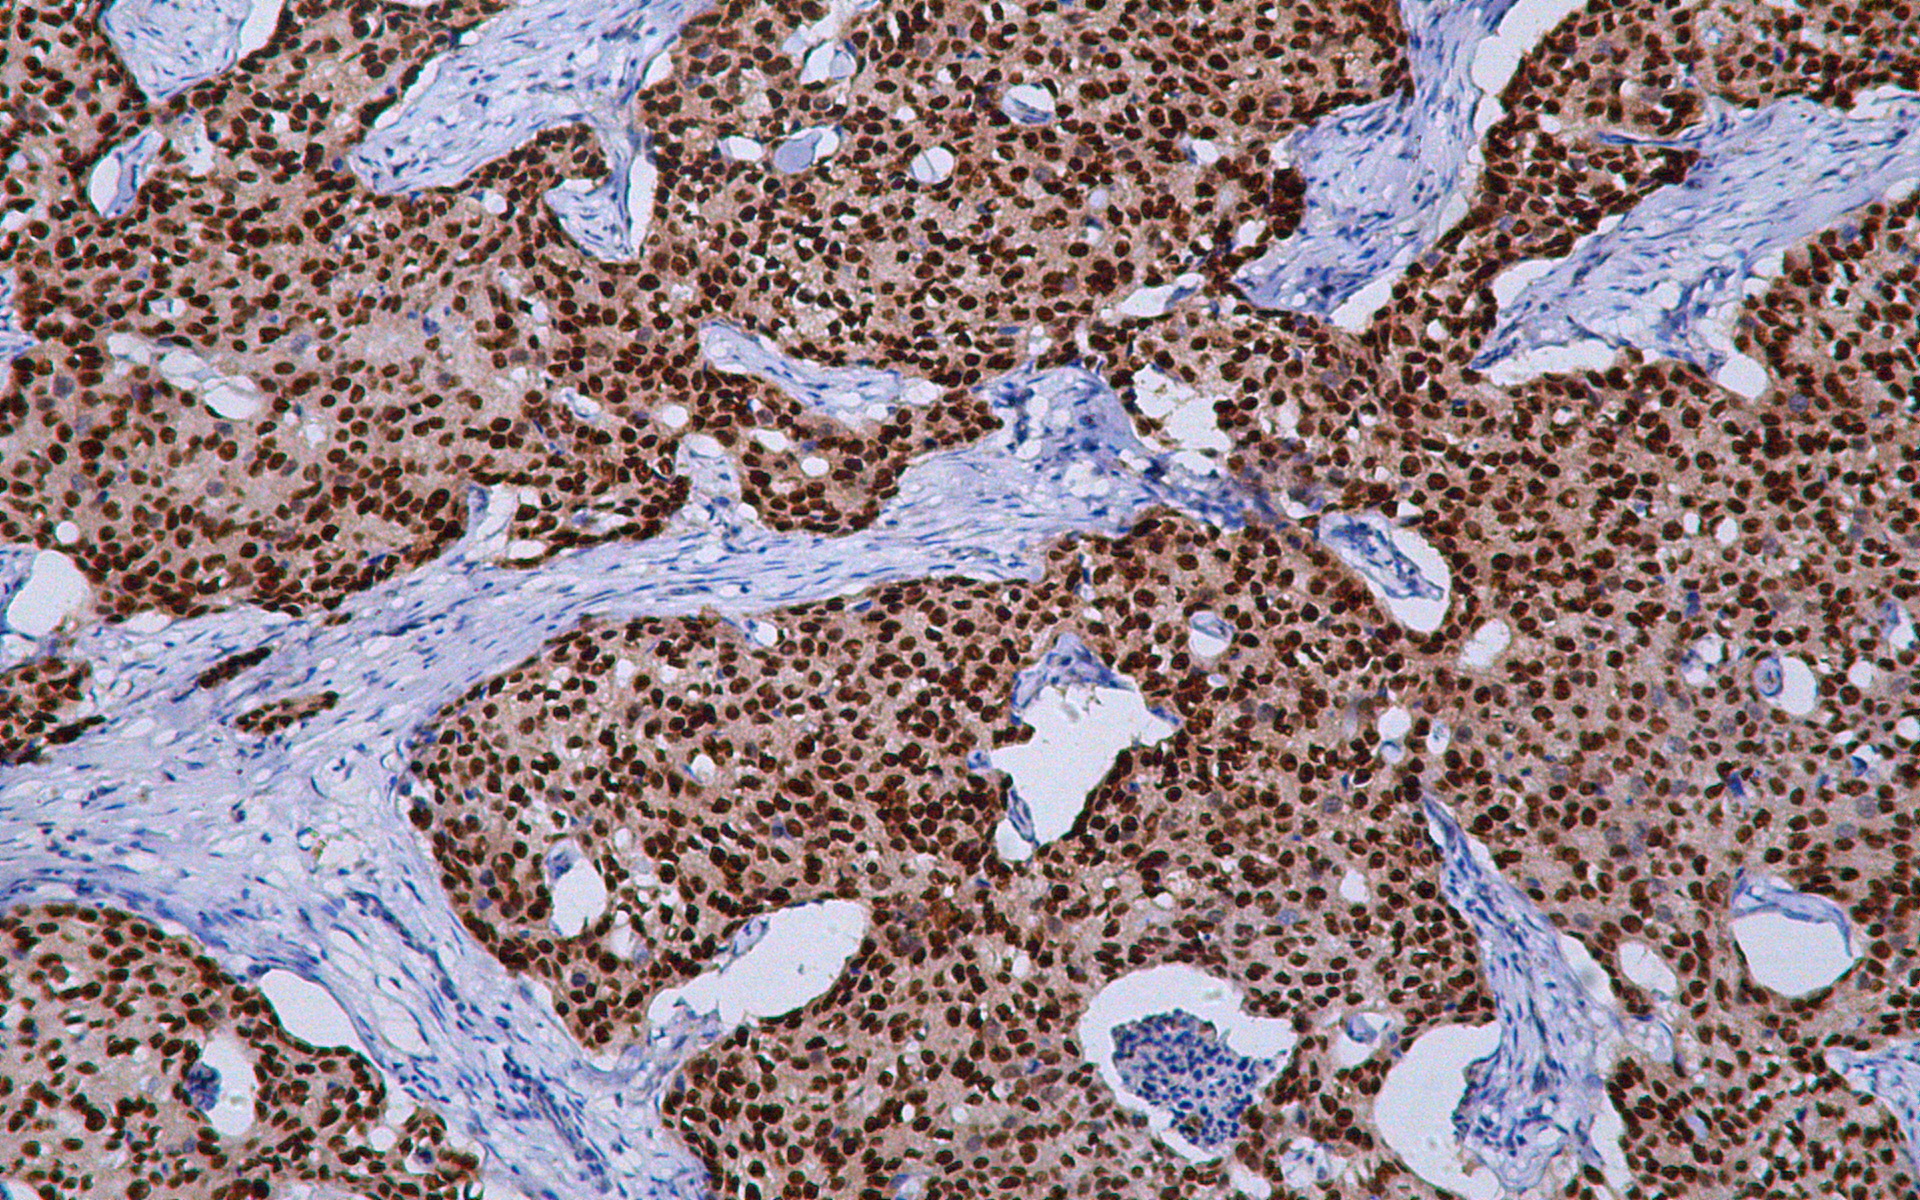
IHC - CD11b AD80462-010

CD11b
Rabbit Monoclonal antibody(Mab)
- SPECIFICATION
- CITATIONS
- PROTOCOLS
- BACKGROUND

Application
| IHC-P |
|---|---|
| Primary Accession | P11215 |
| Reactivity | Human |
| Host | Rabbit |
| Clonality | Monoclonal |
| Clone Names | 263B4D2 |
| Calculated MW | 127179 Da |
| Gene ID | 3169 |
|---|---|
| Gene Name | FOXA1 |
| Other Names | Integrin alpha-M, CD11 antigen-like family member B, CR-3 alpha chain, Cell surface glycoprotein MAC-1 subunit alpha, Leukocyte adhesion receptor MO1, Neutrophil adherence receptor, CD11b, ITGAM, CD11B, CR3A |
| Dilution | IHC-P~~Ready-to-use |
| Storage | Maintain refrigerated at 2-8°C |
| Precautions | FOX A1 Antibody is for research use only and not for use in diagnostic or therapeutic procedures. |
| Name | ITGAM (HGNC:6149) |
|---|---|
| Synonyms | HNF3A, TCF3A |
| Function | Transcription factor that is involved in embryonic development, establishment of tissue-specific gene expression and regulation of gene expression in differentiated tissues. Is thought to act as a 'pioneer' factor opening the compacted chromatin for other proteins through interactions with nucleosomal core histones and thereby replacing linker histones at target enhancer and/or promoter sites. Binds DNA with the consensus sequence 5'-[AC]A[AT]T[AG]TT[GT][AG][CT]T[CT]-3' (By similarity). Proposed to play a role in translating the epigenetic signatures into cell type-specific enhancer-driven transcriptional programs. Its differential recruitment to chromatin is dependent on distribution of histone H3 methylated at 'Lys-5' (H3K4me2) in estrogen-regulated genes. Involved in the development of multiple endoderm-derived organ systems such as liver, pancreas, lung and prostate; FOXA1 and FOXA2 seem to have at least in part redundant roles (By similarity). Modulates the transcriptional activity of nuclear hormone receptors. Is involved in ESR1-mediated transcription; required for ESR1 binding to the NKX2-1 promoter in breast cancer cells; binds to the RPRM promoter and is required for the estrogen-induced repression of RPRM. Involved in regulation of apoptosis by inhibiting the expression of BCL2. Involved in cell cycle regulation by activating expression of CDKN1B, alone or in conjunction with BRCA1. Originally described as a transcription activator for a number of liver genes such as AFP, albumin, tyrosine aminotransferase, PEPCK, etc. Interacts with the cis-acting regulatory regions of these genes. Involved in glucose homeostasis. |
| Cellular Location | Nucleus {ECO:0000255|PROSITE- ProRule:PRU00089, ECO:0000269|PubMed:15987773, ECO:0000269|PubMed:16331276} |
| Tissue Location | Highly expressed in prostate and ESR1-positive breast tumors. Overexpressed in esophageal and lung adenocarcinomas. |

Thousands of laboratories across the world have published research that depended on the performance of antibodies from Abcepta to advance their research. Check out links to articles that cite our products in major peer-reviewed journals, organized by research category.
info@abcepta.com, and receive a free "I Love Antibodies" mug.
Provided below are standard protocols that you may find useful for product applications.
If you have used an Abcepta product and would like to share how it has performed, please click on the "Submit Review" button and provide the requested information. Our staff will examine and post your review and contact you if needed.
If you have any additional inquiries please email technical services at tech@abcepta.com.





Foundational characteristics of cancer include proliferation, angiogenesis, migration, evasion of apoptosis, and cellular immortality. Find key markers for these cellular processes and antibodies to detect them.
The SUMOplot™ Analysis Program predicts and scores sumoylation sites in your protein. SUMOylation is a post-translational modification involved in various cellular processes, such as nuclear-cytosolic transport, transcriptional regulation, apoptosis, protein stability, response to stress, and progression through the cell cycle.
The Autophagy Receptor Motif Plotter predicts and scores autophagy receptor binding sites in your protein. Identifying proteins connected to this pathway is critical to understanding the role of autophagy in physiological as well as pathological processes such as development, differentiation, neurodegenerative diseases, stress, infection, and cancer.